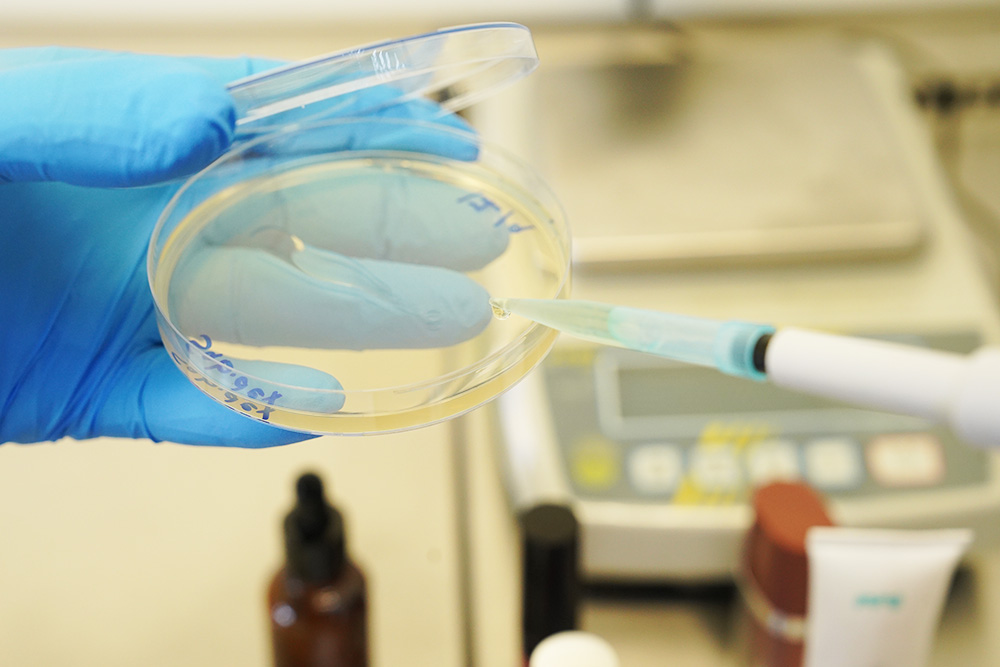

Our Services
Digestive System
More detailsUrologist Clinic
More detailsCardiologist
More detailsEndocrinologist
More detailsDentistry
More details
Our Medical Packages
Health Insurance Plans for Everyone
$1200
Basic Plan
Lorem ipsum dolor sit amet, conse ctetuer adipi scing elit. Nam cursus. Morbi ut mi. Nullam enim leo dolor sit amet.
$3400
Special Plan
Lorem ipsum dolor sit amet, conse ctetuer adipi scing elit. Nam cursus. Morbi ut mi. Nullam enim leo dolor sit amet conse ctetuer adipi scing elit. Nam cursus. Morbi ut mi. Nullam enim leo dolor sit amet.
$4900
Premium Plan
Lorem ipsum dolor sit amet, conse ctetuer adipi scing elit. Nam cursus. Morbi ut mi. Nullam enim leo dolor sit amet.



Make an Appointment
Primary care appointments and some specialties
Our Clients